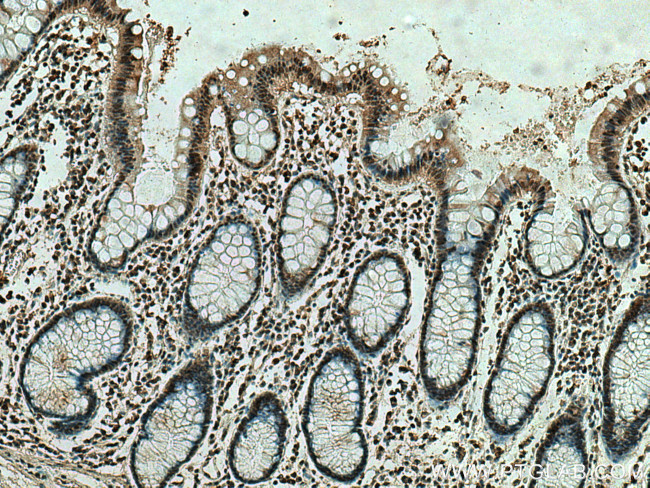
ING4 Antibody in Immunohistochemistry (Paraffin) (IHC (P))

Search
Proteintech
ING4 Monoclonal Antibody (1A12A3)
{{$productOrderCtrl.translations['antibody.pdp.commerceCard.promotion.promotions']}}
{{$productOrderCtrl.translations['antibody.pdp.commerceCard.promotion.viewpromo']}}
{{$productOrderCtrl.translations['antibody.pdp.commerceCard.promotion.promocode']}}: {{promo.promoCode}} {{promo.promoTitle}} {{promo.promoDescription}}. {{$productOrderCtrl.translations['antibody.pdp.commerceCard.promotion.learnmore']}}
产品信息
67754-1-IG
种属反应
宿主/亚型
分类
类型
克隆号
抗原
偶联物
形式
浓度
规格
纯化类型
保存液
内含物
保存条件
运输条件
产品详细信息
Aliquoting is unnecessary for -20°C storage.
靶标信息
The ING4 gene belongs to the ING (Inhibitor of Growth) family of tumor suppressors. All five members of the ING protein family identified to date contain a highly conserved plant homeodomain (PHD) finger motif at the C-terminal end, which is found in transcription factors that modulate chromatin structure. ING proteins have been shown to form transcriptional complexes leading to activation of responsive genes that mediate a wide range of cellular functions, including growth arrest, DNA repair, gene transcription, apoptosis, and senescence. The candidate tumor suppressor ING4 has a role in brain tumor pathogenesis, and is involved in regulating tumor growth and angiogenesis. Expression of ING4 is reduced in gliomas compared to normal brain tissue, and ING4 reduction correlates with progression from lower to higher grades of tumors. ING4 physically interacts with the p65 (RelA) subunit of NF-kB and represses transcription of NF-kB responsive genes. Inactivating mutations in ING4 transcripts have been described in various human cancer cell lines, and deletion of the ING4 locus has been detected in 10-20% of human breast cancer cell lines and tumors.
仅用于科研。不用于诊断过程。未经明确授权不得转售。
篇参考文献 (0)
生物信息学
蛋白别名: brain my036 protein; candidate tumor suppressor p33 ING1 homolog; Inhibitor of growth protein 4; p29ING4; unnamed protein product
基因别名: ING4; My036; p29ING4
UniProt ID: (Human) Q9UNL4
Entrez Gene ID: (Pig) 102161011, (Human) 51147, (Rabbit) 100340491, (Rat) 297597